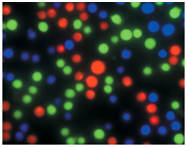

https://www.liankebio.com/article-information_Newsletter-1157.html
作者:Life官网 发布日期:2014-06-03 07:00
 Molecular Probes® 荧光细胞追踪剂和神经示踪剂是用于跟踪复杂环境中细胞的重要工具,已广泛应用于细胞迁移、创伤愈合及干细胞分化研究。这些探针在工作浓度下稳定无毒,可在细胞内保留完好(从几小时到几天),并在生理pH值下发出亮荧光。 此外,Life Technologies可提供覆盖光谱的各种荧光发射光颜色,能够同时检测细胞运动及其他重要的细胞功能。 表 1. Molecular Probes® 荧光细胞追踪探针和示踪剂。
一、 钙黄绿素 AM 探针 传统的非固定钙黄绿素探针是适用于细胞示踪和活性研究的示踪剂。这些示踪剂含有可阻断分子上负电荷的乙酰氧基甲酯(AM)基团,便于其穿过细胞膜。进入细胞后,非特异性的酯酶会切掉AM,生成细胞非透过性的极性分子,高效保留在细胞内数小时。与下述的 CellTracker™和 CellTrace™探针不同,钙黄绿素AM探针只能保留在活细胞内。当与细胞非透过性的核酸染料(如SYTOX® Green染料或PI) 结合使用时,钙黄绿素示踪剂可利用显微镜或流式细胞仪高效区分活细胞和死细胞。钙黄绿素探针易于操作,有效时间为2-8 小时,具体取决于细胞类型。
二、 CellTracker™ 探针 CellTracker™ 荧光探针可自由通过细胞膜,转变为细胞非透过性的反应产物。这种细胞非透过性质可在细胞中存留多代,但不会转移至群体中相邻的细胞内。导入CellTracker™探针的细胞通常可发出荧光,至少24小时内均可观察到,因此,这些探针是极佳的长期细胞示踪剂。此外,采用甲醛或戊二醛可固定染色形态,长期保存标记细胞或组织,有利于潜在的病原体样本的安全处理,且与抗染料抗体结合使用时,可实现信号放大。CellTracker™探针不会转移至群体中相邻的细胞内,是适用于移植细胞或组织的长期示踪剂。通常采用荧光显微镜监测 CellTracker™探针的信号,探针有多种荧光颜色可供选择,适用于多色分析。
三、 CellTrace™ 探针 CellTrace™探针亦可极好地保留在细胞内,一旦它们与蛋白质或其他含有胺基的生物分子反应,经甲醛固定后,仍可存留在细胞内。这些胺基反应性细胞示踪剂——包括CellTrace™ Violet、CellTrace™ CFSE和 CellTrace™ Far-Red DDAO-SET探针——均含有琥珀酰亚胺酯,可与细胞内外的伯胺反应。采用CellTrace™ Violet探针染色明亮均匀,群体中细胞间的荧光差异极小,可在荧光直方图上观察增殖细胞的不同代数。 四、 Qtracker® 探针 Qtracker®细胞标记试剂盒——提供七种颜色的Qdot®纳米晶体——包含将Qdot®纳米晶体导入活细胞所需的试剂,为长期实时追踪研究提供了一种高效的方法。这些Qdot®纳米晶体含有一种目标多肽,可被细胞选择性地摄取,分布于整个细胞质的囊泡内。在细胞内,Qdot®纳米晶体可发出光稳定性的强荧光,在连续照明下可观察到,且不会因光漂白作用或降解而消失。在复杂的细胞环境以及不同的生物学状态下(包括细胞内pH 值、温度和代谢活性的改变)均能保持荧光,且可以传递至子代细胞内,至少7代,或者维持至少8天(U2OS细胞)。Qtracker®细胞标记试剂盒可用于各种应用领域,包括造血干细胞的体内追踪、注入神经移植物后Schwann细胞的追踪以及感染的皮肤创伤内的中性粒细胞存活检测。在小动物的体内血管成像应用中,可将Qtracker®非靶向量子点注射至小鼠的尾静脉,利用小动物体内成像(SAIVI™)技术进行血管结构研究。这些纳米晶体可发出强荧光,并出现发射光红移,使组织穿透性增加,消除本底自发荧光,PEG表面包覆可使非特异性反应最小化,降低免疫应答反应。由于 PEG 表面包覆不含反应性功能基团,因此Qtracker®非靶向量子点可以更长时间保留在循环系统内,一次注射的成像时间达3小时,多次注射则可维持更长时间。
五、CellLight® 试剂 CellLight®试剂为即用型emGFP和TagRFP融合重组体,可用于非靶向、细胞骨架靶向或细胞器靶向荧光蛋白的表达。CellLight®细胞质标记物——又称为BacMam GFP转导对照——可在各种类型细胞的胞浆和细胞核中表达emGFP。瞬时转导的标准细胞系一般表达荧光融合蛋白约5天 (如HeLa和CHO)。在缓慢分裂的细胞中——如一些原代细胞——可表达至多2周,在终末分化的神经元中,可观察到在转导之后表达超过3周。 六、神经示踪 1、可固定的极性示踪剂 Life Technologies制备了各种高水溶性染料及其他检测探针,可用作细胞示踪剂。Molecular Probes®可固定极性示踪剂包括膜不通透性探针荧光黄和Alexa Fluor®酰肼。在大多数情况下,这些水溶性探针的极性极高,不能通过被动扩散的方式进入细胞膜。因此,必须采用特殊的方法将探针导入细胞,包括显微注射、胞饮作用或细胞膜暂时透化技术。通常采用显微注射法导入探针,它们可用于各种应用领域,包括神经示踪、细胞间及细胞-脂质体融合、膜通透性、间隙连接介导的转运及胞饮介导的细胞摄取研究。在醛基固定过程中,这些荧光酰肼衍生物可与周围的生物分子共价连接,以便继续进行抗体分析。 荧光黄和磺酰罗丹明101 (橙/红)是应用广泛的示踪剂,必须通过注射导入。这些极性示踪剂可在整个细胞内均匀分布,是极佳的神经细胞显示工具。采用这些染料还可观察间隙连接。
2、膜示踪剂 可直接使用单独的或试剂盒内(Vybrant®细胞标记溶液)的亲脂性二烷基碳菁类染料,包括 DiI、DiO、DiD、DiR、FM® 1-43 和FM® 4-64,穿过细胞膜。这些染料通过侧向扩散对整个细胞进行染色。这些探针被广泛用作活组织和固定组织中的顺行和逆行示踪剂及长期细胞间结合分析,有多种荧光颜色和形态 (固态、溶于有机溶剂、悬浮于糊剂及大晶体)可供选择。 利用针尖,可将即用型NeuroTrace® DiI和DiO组织标记糊剂直接用于组织,使染料渗入神经束,标记其表面上下的轴突。我们还可提供 NeuroTrace® 多色组织标记试剂盒,包含DiI、DiO和DiD糊剂,以及亲脂性示踪剂采样试剂盒,包含DiI、DiO、DiD、DiR和DiA类似物。
3、荧光葡聚糖结合物 荧光葡聚糖结合物(如Alexa Fluor®葡聚糖)是理想的细胞系示踪剂,具有惰性、低毒性的优点,可长时间保留于细胞内。葡聚糖有各种分子量可供选择,是适用于测定细胞膜孔径的分子排阻探针。通常可通过显微注射、全细胞膜片钳或电穿孔法将其导入细胞内。 荧光和生物素化的葡聚糖常用于示踪神经元投射。葡聚糖可用作顺行和逆行示踪剂,具体取决于研究方法和使用的组织类型。葡聚糖的主动运输仅发生在活组织内,而非固定组织。分子量达70,000道尔顿的葡聚糖结合物已在各种种属中被用作神经示踪剂。 4、荧光微球 FluoSpheres®和TransFluoSpheres®聚苯乙烯荧光微球是具有强荧光且持久的惰性示踪剂。这些微球主要用作长期标记物,适用于移植研究。可将它们注射至细胞内或者通过细胞吞噬作用摄入。这些微球满足了理想的长期生物学示踪剂的几个先决条件。由于我们的染料并非仅仅是结合在微球表面上,而是掺入到整个微球内,因此每个微球的荧光输出量明显高于蛋白质或葡聚糖结合物的荧光强度,它们相对不易受光漂白作用和其他环境因素的影响。FluoSpheres®和TransFluoSpheres®微球还具有生物学惰性和物理学持久性,有各种均一大小和表面特性可供选择。此外,在生产过程可对其光谱特性进行自由处理,且不改变表面特性。5、蛋白和蛋白结合物 蛋白示踪剂的分子量范围约为12,000 (霍乱毒素B亚基结合物)至240,000 (B-和R-藻红蛋白)。Molecular Probes®霍乱毒素结合物仅由重组的B亚基构成。这使得我们能够提供一种完全不含毒性A亚基的高纯度产物。霍乱毒素B亚基(CT-B)通过与神经节苷脂GM1结合,粘附于细胞上,是一种高效的神经元逆行标记工具。该示踪剂已被广泛应用于各种应用领域,包括大鼠前脑传入、臂旁区投射和膀胱壁神经元示踪。在神经示踪应用领域,CT-B常通过压注或离子渗透的方式导入神经组织内。 如白蛋白和卵清蛋白等其他蛋白结合物常用作靶向受体,检测蛋白酶活性及细胞内pH。 6、神经示踪染料及试剂盒 Nissl染色是一种标准的组织学方法,可用于脑及脊髓神经元的反向示踪。Nissl体由神经元核周体和树突内的粗面内质网相关的核糖体RNA组成,在损伤或再生神经元的细胞体内会重新分布,是一种神经元生理状态的标记物。Life Technologies的NeuroTrace® Nissl染料可选择性地结合神经元特征性Nissl体,灵敏度高于传统的组织学染料,如甲苯胺蓝或甲酚紫。这些 Nissl染料有多种荧光颜色可供选择,可单独进行神经元染色,亦可与特异性蛋白的免疫荧光染色相结合。 采用BrainStain™成像试剂盒,可对脑部冰冻切片中的髓鞘、神经元和细胞核进行三色组合标记,只需20分钟的染色及冲洗步骤即可完成。该试剂盒含有新型染料,可单独使用或者与染液结合使用,可替代耗时1-3天的传统方法。标准的组织化学方法(如免疫组化)可与该染料相兼容。BrainStain™试剂盒包括: (1)、FluoroMyelin™髓鞘绿色荧光染料 (2)、NeuroTrace® 530/615红色荧光Nissl染料 (3)、DAPI胞核复染剂
|